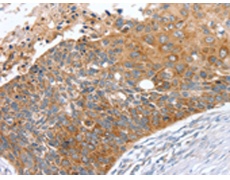
一抗

|
Background: |
This gene encodes a member of the sorting nexin family, a diverse group of cytoplasmic and membrane-associated proteins involved in endocytosis of plasma membrane receptors and protein trafficking through these compartments. All members of this protein family contain a phosphoinositide binding domain (PX domain). A highly similar protein in mouse is responsible for the specific recruitment of an isoform of serotonin 5-hydroxytryptamine 4 receptor into early endosomes, suggesting the analogous role for the human protein. |
|
Applications: |
ELISA, IHC |
|
Name of antibody: |
SNX27 |
|
Immunogen: |
Fusion protein of human SNX27 |
|
Full name: |
sorting nexin family member 27 |
|
Synonyms: |
MRT1; MY014 |
|
SwissProt: |
Q96L92 |
|
ELISA Recommended dilution: |
2000-5000 |
|
IHC positive control: |
Human esophagus cancer |
|
IHC Recommend dilution: |
25-100 |

 購物車
購物車 幫助
幫助
 021-54845833/15800441009
021-54845833/15800441009